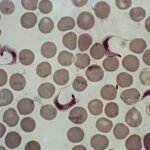

En aquest espai us acostem a la malaltia de Chagas per mitjà de la paraula d’en Pere Albajar i els espots gravats amb la col·laboració del futbolista Leo Messi dins la campanya Guanya al silenci, guanya a la malaltia de Chagas.
L’entrevista
Al finalitzar la xerrada d’en Pere Albajar del 21 de març de 2014 a les Cases dels Mestres de Caldes, Ràdio Caldes li realitzà l’entrevista que podeu escoltar a continuació (a partir del minut 31) :
Guanya al silenci, guanya a la malaltia de Chagas
El futbolista professional Leo Messi col·labora en la lluita contra la malaltia de Chagas. La campanya “Guanya al silenci, guanya a la malaltia de Chagas” és una iniciativa de la Fundació Leo Messi i la Fundació FC Barcelona, també participen el Programa de salut internacional de l’Institut Català de la Salut (PROSICS) i l’Organització Mundial de la Salut (OMS), entre d’altres.
Aquesta és una campanya de sensibilització que va veure llum al 2012 per conscienciar a aquelles persones amb risc d’estar infectades sobre la importància de fer-se les proves de diagnòstic i els tractaments oportuns quan escau. En aquest any es va difondre el primer espot amb la participació de Leo Messi i al 2015 s’ha publicat el segon espot. Una mica abans, al 2014, nasqué el portal BeatChagas (http://beatchagas.org) per sensibilitzar les persones, institucions diverses i governs sobre la complexitat de la problemàtica d’aquesta malaltia.
Espot 2012
Espot 2015